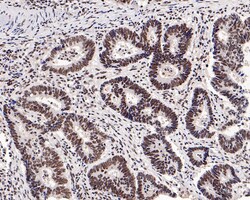
Invitrogen CBP Recombinant Rabbit Monoclonal Antibody (PS01-16) 100 &mu;L;

missing translation for 'onlineSavingsMsg'
Learn More
Learn More
Invitrogen™ CBP Recombinant Rabbit Monoclonal Antibody (PS01-16)
Rabbit Recombinant Monoclonal Antibody
Brand: Invitrogen™ MA556562
This item is not returnable.
View return policy
Description
CBP Recombinant Monoclonal Antibody for IHC (P)
CBP for CREB-binding protein is a 265 kDa nuclear protein which probably has many of the properties expected of a CREB co-activator. It shows substantial sequence homology with p300.
Specifications
| CBP | |
| Recombinant Monoclonal | |
| 1 mg/mL | |
| PBS with 0.1% BSA, 40% glycerol and 0.05% sodium azide; pH 7.4 | |
| P45481, Q92793 | |
| CREBBP | |
| Synthetic peptide within Human CREBBP aa 2400-2500. | |
| 100 μL | |
| Primary | |
| Human, Mouse | |
| Antibody | |
| IgG |
| Immunohistochemistry (Paraffin) | |
| PS01-16 | |
| Unconjugated | |
| CREBBP | |
| AW558298; CBP; CBP/p300; CREB binding protein; CREB-binding protein; CREBBP; KAT3A; p300/CBP; RSTS; RTS | |
| Rabbit | |
| Protein A | |
| RUO | |
| 12914, 1387 | |
| Store at 4°C short term. For long term storage, store at -20°C, avoiding freeze/thaw cycles. | |
| Liquid |
Product Content Correction
Your input is important to us. Please complete this form to provide feedback related to the content on this product.
Product Title
Spot an opportunity for improvement?Share a Content Correction